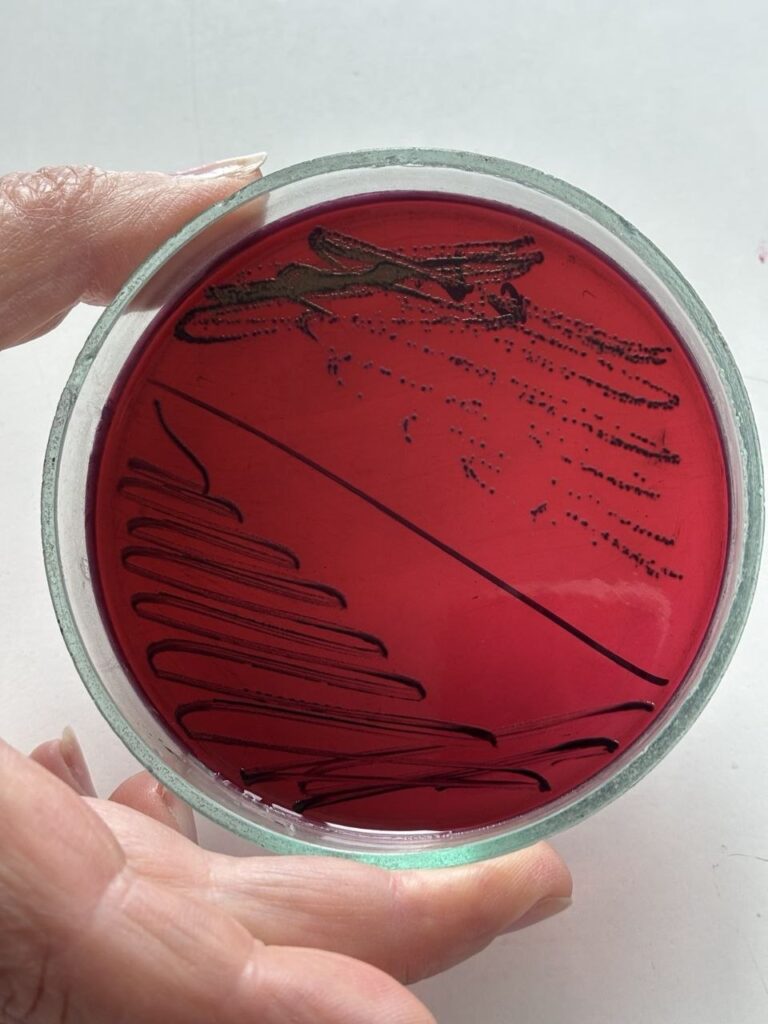

У Шполянській громаді триває щоденний моніторинг стану довкілля, якості питної води та рівня захворюваності населення. Фахівці відстежують радіаційний фон, досліджують повітря й воду та аналізують епідемічну ситуацію.
Завідувачка Шполянського відділення Звенигородського районного відділу ДУ «Черкаський ОЦКПХ МОЗ» Марія Михайленко розповіла про результати спостережень та основні ризики для здоров’я населення.
«З метою недопущення гострих і хронічних отруєнь та інфекційних захворювань ми продовжуємо проведення моніторингових лабораторних досліджень об’єктів довкілля. Щоденно здійснюється контроль гама-випромінювання - тричі на добу, а також перевіряється якість та безпечність питної води і ведеться епідемічне спостереження», - зазначає Марія Михайленко.
За її словами, радіаційний фон у регіоні залишається стабільним.
«Упродовж 2026 року перевищень рівнів гама-випромінювання не зафіксовано. Середній показник становить 0,12-0,14 мкЗв/год і відповідає вимогам Норм радіаційної безпеки України», - пояснює вона.
Не викликає занепокоєння і стан атмосферного повітря.
«Рівні діоксиду азоту, пилу та аміаку в пробах повітря перебувають у межах допустимих концентрацій», - додає фахівчиня.

Також стабільною залишається ситуація з централізованим водопостачанням.
«Проби води з мереж КП «Комунальник» у Шполі та Лебедині відповідають вимогам державних санітарних норм за всіма дослідженими показниками», - зазначає Марія Михайленко.
Водночас серйозною проблемою залишаються криниці у приватному секторі.
«На жаль, зберігається тенденція до погіршення якості води в колодязях. У кожній третій дослідженій пробі виявлено перевищення вмісту нітратів понад норму», - застерігає вона.
Окрему увагу вона звертає на епідемічну ситуацію в регіоні.
«Ускладнюється ситуація з туберкульозом. У 2025 році було виявлено 21 випадок активної форми захворювання, що майже вдвічі більше, ніж у 2024-му. Від початку 2026 року вже зареєстровано 13 випадків», - повідомляє Марія Михайленко.
Ще одним фактором ризику є зростання кількості безпритульних тварин.
«Збільшення кількості безпритульних собак і котів та напади на людей можуть призвести до ускладнення ситуації зі сказом. Від початку року зареєстровано 28 випадків укусів, серед постраждалих - шестеро дітей до 14 років», - каже вона.
Водночас ситуація із сезонними захворюваннями наразі контрольована.
«Рівень захворюваності на грип та ГРВІ не перевищує епідпоріг. За тиждень з 18 по 24 квітня 2026 року захворіло 178 жителів громади, що на 15% менше, ніж попереднього тижня, з них 122 (68,5%) - діти до 17 років. Переважна кількість - 112 - це діти шкільного та дошкільного віку, кількість яких, у порівнянні з минулим тижнем, зменшилась всього на 12», - зазначає фахівчиня.
Загалом із початку року в регіоні на грип та ГРВІ захворіло понад три тисячі осіб.
«Від початку року зафіксовано 3227 випадків, фактично це кожен дванадцятий житель громади, з них понад половина - діти», - додає вона.
Марія Михайленко підкреслює, що ситуація з інфекційними захворюваннями, пов’язаними з водою чи продуктами харчування, залишається стабільною.
«Випадків інфекційних захворювань, пов’язаних із водопостачанням або харчовими продуктами, а також інфекцій, що мають міжнародне значення, у регіоні не зареєстровано».